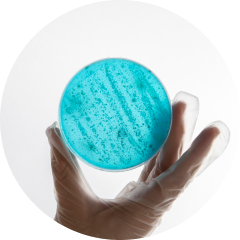

Активные компоненты: активные молекулы чайного дерева Rgenight, экстракт ледниковой бактерии IceAwake, синергетический отшелушивающий комплекс, биодоступный кремний, низкомолекулярная гиалуроновая кислота, ниацинамид, трутовик лакированный, ценные масла.
Ингредиенты (INCI): Aqua (water), Panthenol, C15-19 Alkane, Behenyl Alcohol, Isopropyl Palmitate, Niacinamide, Camelina Sativa (Camelina) Seed Oil, Caprylic/Capric Triglyceride, Butyrospermum Parkii (Shea) Butter, Propanediol, Polyglyceryl-2 Stearate, Pinus Sibirica (Cedar) Seed Oil, Triheptanoin, Glyceryl Stearate, Stearyl Alcohol, Spondias Mombin Pulp Extract, Mangifera Indica (Mango) Pulp Extract, Musa Sapientum (Banana) Pulp Extract, Acacia Senegal Gum, Ganoderma Lucidum Extract, Inonotus Obliquus Extract, Nigella Sativa (Caraway) Seed Oil, Sodium Hyaluronate, Melatonin, Glycerin, Cordyceps Sinensis Extract, Phospholipids, Methylsilanol Mannuronate, Melaleuca Alternifolia (Tea Tree) Leaf Oil, Maltodextrin, Succinic Acid, Tocopherol, Xanthan Gum, 1,2-Hexanediol, Caprylhydroxamic Acid, Lactobacillus Ferment, Parfum, Benzyl Alcohol, Potassium Sorbate, Citric Acid, Limonene, Linalool.


Высочайшее качество обеспечивает собственное производство, которое сертифицировано по самым строгим международным стандартам и внесено в реестр FDA.